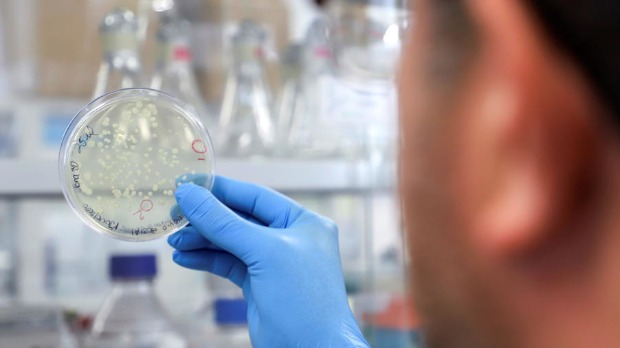

Резултати претраге
Термин претраге: nike air max pre day lx phantom black , Погодака: 59172
30. 03. 2021.
Pupovac: Pomogao sam Milanoviću da postane predsednik, ne očekujem izvinjenje
Predsednik Samostalne demokratske srpske stranke (SDSS) Milorad Pupovac rekao je u radio-emisiji 'U mreži' da ne očekuje izvinjenje od predsednik Zorana Milanovića iako mu je, kako kaže, pomogao da postane predsednik, nakon čega doživljava ponižavanja i poruke od 'najcrnjih fašista u Hrvatskoj'.
... , napisao je Milanović. Milorad Pupovac, koji je pre nekoliko dana objavio optužbe i uvredljive poruke ...
30. 03. 2021.
Pižon za RTS: Piksi dugoročno rešenje za selektora, danas najteži meč
Vladimir Petrović Pižon, nekadašnji reprezentativac Jugoslavije, četvrta Zvezdina zvezda i čovek koji je ostavio veliki trag u domaćem i evropskom fudbalu, veruje da je Dragan Stojković Piksi pravo i dugoročno rešenje za mesto selektora. Pižon je gostujući u Jutarnjem programu RTS-a govorio o nacionalnom timu i početku kvalifikacija za Svetsko prvenstvo u Kataru 2022.
... promovisan nekoliko sedmica pre okupljanja, kao i da su važne utakmice na startu kvalifikacija došle u ne ...
29. 03. 2021.
Šta je piscu prva rečenica
Prva rečenica je kao prvo dete u knjizi, kazali bi skloni romantičnom poimanju literature. Prva rečenica je kao vatromet koji najavljuje feštu zvana knjiga, rekli bi drugi, skloniji spektakularizmu.
... je svega nekoliko taktova reskih udaraca timpana pre čuvenog prvog akorda soliste. U književnosti ...
27. 03. 2021.
Srce i karakter Piksijevih 'orlova', sudije pomogle Srbiji da izvuče remi
Fudbaleri Srbije pokazali su veliko srce, borbenost i karakter i odigrali nerešeno 2:2 sa Portugalijom, u drugoj utakmici kvalifikacija za Svetsko prvenstvo u Kataru 2022. godine. 'Orlovi' su protiv aktuelnog evropskog šampiona odigrali dva potpuno različita poluvremena i uspeli da nadoknade minus od dva gola, čime su zadržali prvo mesto na tabeli grupe A.
... gol za trijumf, lopta je prešla gol-liniju pre nego što je Stefan Mitrović izbio, ali arbitri to nisu ...
27. 03. 2021.
Pogledi na 27. mart – 80 godina kasnije
Težak, ali ispravan put koji je Kraljevinu Jugoslaviju uveo u rat – tako se osam decenija kasnije govori o 27. martu. Taj datum je u istoriju upisan kao dan kada su gradovima širom Srbije održane masovne demonstracije protiv pristupanja Jugoslavije Trojnom paktu. Vojnim udarom svrgnuti su knez Pavle Karađorđević i Vlada Cvetković-Maček. Na presto je doveden maloletni kralj Petar Drugi Karađorđević i formirana Vlada koju je predvodio general Dušan Simović.
... unutrašnjepolitičkim razlozima. Pre svega prirodom samog režima, politikom kneza Pavla i vlade, političkim ...
27. 03. 2021.
Kuvalja: Obrenovac je ponos trke Beograd - Banjaluka
Prvi put u istoriji, Obrenovac će biti domaćin etape na našoj najjačoj biciklističkoj trci Beograd - Banjaluka. Prošle godine, Obrenovac je takođe prvi put bio zvanično i domaćin prolaznog cilja.
... 14 godina Obrenovac je konstantno bio na ruti trke, jer uvek započinjemo trku iz Beograda. Pre dve ...
27. 03. 2021.
Promene koje će, možda, doneti kraj jedne ere u Formuli 1
Počinje nova sezona u Formuli 1 uz nova pravila koje su stupila na snagu ove godine. Koji su razlozimi i ciljevi njihovog uvođenja i hoće li rezultati ispuniti očekivanja. Jesu li debitanti novim pravilima u ravnopravnijem položaju u odnosuna iskusnije vozače koji se smatraju favoritima?
... . Prva se odnosi na ograničenje troškova, pravilo koje nam je poznato pre svega iz američkih ...
27. 03. 2021.
Ko se sahranjuje u Aleji zaslužnih građana, a ko u Aleji velikana
U Aleji zaslužnih građana na beogradskom Novom groblju počivaju mnoge znamenite ličnosti. Direktor JKP Pogrebnih usluga Dragan Baltovski kaže za RTS da je gradskim propisima tačno utvrđeno ko će tamo biti sahranjen, napominjući da poslednju reč daje gradonačelnik srpske prestonice.
... minimalne u odnosu na period pre pandemije. Radnici su obučeni da se pobrinu za preminule od ...
26. 03. 2021.
Miris i ukus
Gubitak čula mirisa (anosmija) i smanjeni ili izgubljeni osećaj ukusa (ageuzija) simptomi su koji su opisani u većini zemalja tokom pandemije koronavirusa. Usled bliske funkcionalne aktivnosti dva hemosenzorna sistema, kod pacijenata je oslabljena percepcija ukusa udružena sa poremećajem mirisa.
... najstarijim, podsvesnim delovima mozga, što omogućava aktiviranje intenzivnih emocija i sećanja pre nego ...
25. 03. 2021.
Zamrzivač dobro dođe u svakoj kući, ali i zaleđena hrana ima rok trajanja
Tokom čitave istorije, ljudi su oduvek ulagali puno napora da sačuvaju hranu. Zaleđeno voće, povrće, meso, riba prvi put su u pakovanjima ponuđeni kupcima u Sjedinjenim Američkim Državama 1930. godine, a do 1940. taj način čuvanja hrane postao je široko rasprostranjen. Međutim, kada treba isprazniti zamrzivače i koliko dugo smemo da jedemo turšiju, marmeladu ili pijemo domaće sokove?
... pripreme pre toga, može doći i do pjave crevnih bolesti, tzv. alimentarnih infekcija, ukoliko posle toga ne ...
25. 03. 2021.
Srđa Janković: Neprimereno je da u ovakvoj situaciji pričamo o otvaranju kafića
Imunolog i član Kriznog štaba Srđa Janković ističe za RTS da je procenat pozitivnih među testiranima i dalje jako visok, dodajući da su bolnice prepune. Kaže da situacija prvo mora da se smiri pa da se onda govori o otvaranju ugostiteljskih objekata i tržnih centara.
... trenutku masovnog zaražavanja vrlo izazovno. Mnogo je onih koji su se zarazili pre vakcine, i ...
24. 03. 2021.
Glumica Tijana Marković tvrdi da je lik Marije Milošević u seriji „Porodica“ izabrao nju
Od 29. marta na RTS-u se emituje mini-serija „Porodica“ koja daje dramski prikaz zbivanja u poslednjih 48 sati pred hapšenje nekadašnjeg predsednika Jugoslavije, Slobodana Miloševića. Uloga ćerke Marije Milošević pripala je glumici Tijani Marković.
... Serija Porodica je, kako naglašava glumica Tijana Marković, pre svega priča o porodici. Naravno ...
24. 03. 2021.
Pogled istoričara na bombardovanje - jedina ratna akcija NATO u Evropi, šta Srbi nisu mogli da shvate
Dan koji se ne zaboravlja je 24. mart 1999. godine – kada su počeli vazdušni napadi na Saveznu Republiku Jugoslaviju. Za 78 dana poginulo je između 1.200 i 3.000 ljudi. Istričar Predrag Marković rekao je za RTS da u to vreme Srbi nisu mogli da shvate da naši stari saveznici, Amerikanci, Britanci mogu da nam to urade - to je prvi napad NATO pakta u istoriji.
... , javni servis ima misiju, daleko će pre poslati poruku, zato treba država da podrži javni servis, da ...
22. 03. 2021.
Vučić: Vakcinisaću se i snimiti, da svi mogu da vide
Predsednik Srbije Aleksandar Vučić najavio je da će u narednih nekoliko dana primiti vakcinu protiv koronavirusa i da u kampanju vakcinacije po Srbiji kreće krajem marta ili početkom aprila.
... da taj apel upućuje pre svega predstavnicima vlasti, jer, kako kaže, kod onih sa Mauricijusa i iz ...
21. 03. 2021.
Šta treba da znate ako želite da proverite antitela posle vakcine
Najbolje vreme da se provere antitela je dve nedelje posle revakcine, ali treba se dobro raspitati koji test uraditi kako bi pokazao pravu sliku, rekla je doktorka Marija Gnjatović iz Instituta za primenu nuklearne energije. Posle vakcine važno je da ELISA test bude baziran na primeni S proteina, kaže Gnjatovićeva.
... koronavirusu, kaže doktorka i naglašava da je zato važno raspitati se pre nego što uradite test na antitela ...
21. 03. 2021.
Trećina domaćinstava u Srbiji se greje na drva, da li su šume u Srbiji u opasnosti
Danas se u celom svetu obeležava Svetski dan šuma. Čini se da nikada ranije nismo u toj meri odlazili na planine i boravili na čistom vazduhu, išli na izletišta i uopšte cenili šume nego od početka pandemije. Nažalost, godišnje u svetu nestane oko 16 miliona hektara ovih zelenih prostranstava, neophodnih za prirodnu ravnotežu života na Zemlji. Da li su u opasnosti srpske šume otkrio je za RTS Vladimir Nikolić iz Uprave za šume Ministarstva poljoprivrede Srbije.
... koje su pre 100 godina bile šume pa bile iskrčene zbog poljoprivrednog zemljišta polako se vraćaju ...
20. 03. 2021.
Strategija Angele Merkel: Brža vakcinacija i 'kočnica u slučaju opasnosti'
'Moto glasi: vakcinisati, vakcinisati, vakcinisati“, sažela je kancelarka strategiju nakon sastanka sa pokrajinskim premijerima u petak uveče. A u ponedeljak verovatno sledi odluka – o novom lokdaunu.
... kancelarka. Na zajedničkoj konferenciji za štampu u petak pre podne, savezni ministar zdravlja Jens Špan ...
20. 03. 2021.
Kostić nastavlja dominaciju u Bundesligi, Bajern i Levandovski nemilosrdni
Srpski reprezentativac Filip Kostić nastavlja sa fantastičnim partijama u Bundesligi i vodi svoj Ajntraht ka Evropi, dok Bajern Minhen ne namerava da posustane u odbrani titule. Ajntraht je uz još jednu sjajnu predstavu Kostića pobedio Union Berlin sa 5:2, dok je Bajern uprkos igraču manje deklasirao Štutgart u 26. kolu. U ostalim mečevima Keln i Borusija Dortmund su remizirali 2:2, Volfsburg je sa 2:1 slavio u Bremenu, baš kao i Borusija Menhengladbah u Gelzenkirhenu – 3:0.
... bio kraj golovima u prvom poluvremenu – Silva je drugim pogotkom povisio rezultat, pre nego što je ...
19. 03. 2021.
Džon Kenedi za RTS: Oba roditelja imaju podjednaku ulogu u vaspitanju
Nekada je važilo pravilo, posebno u kulturi kakva je naša, da je uloga majke u vaspitanju deteta mnogo važnija od uloge oca. Majka je bila ta koja se brine, angažuje i usmerava decu, dok je otac 'spoljni igrač', tj. neko ko brine o finansijskoj sigurnosti porodice i dece. Međutim, očevi i njihova uloga u porodici se danas mnogo razlikuje. Postali su roditelji sa podjednakom odgovornošću kao i majke.
... porodicu, pre svega njihovo psihofizičko zdravlje je bolje, odnosi sa partnerkom su bolji, deca imaju ...
19. 03. 2021.
Klasa 'mart 2021' položila zakletvu, Stefanović: Ko izabere da bude vojnik, zaslužuje posebno poštovanje
Više od 400 vojnika na dobrovoljnom služenju vojnog roka i slušalaca Kursa za rezervne oficire generacije 'mart 2021' položilo je zakletvu u kasarnama u Leskovcu, Somboru, Valjevu i Beogradu.
... porodična tradicija ono što ga je, pre svega, navelo da dobrovoljno služi vojni rok, ali i mogućnost ...